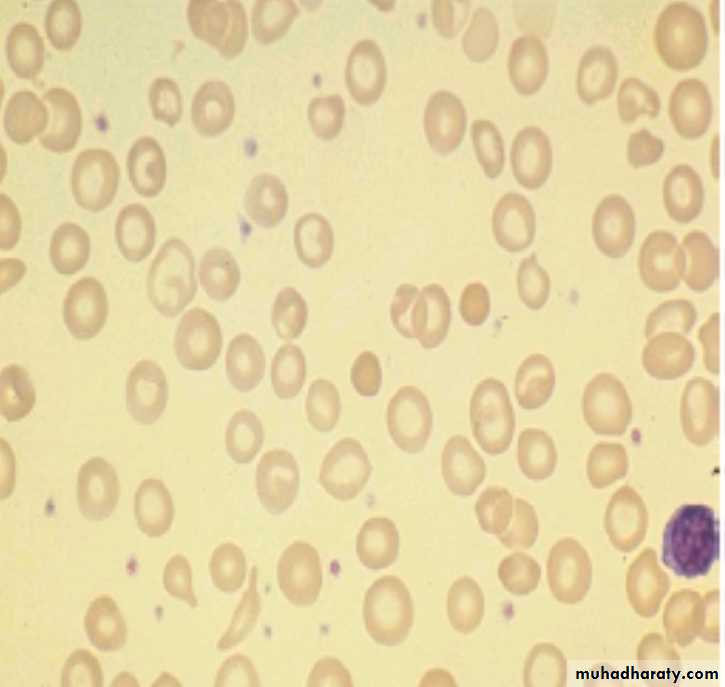
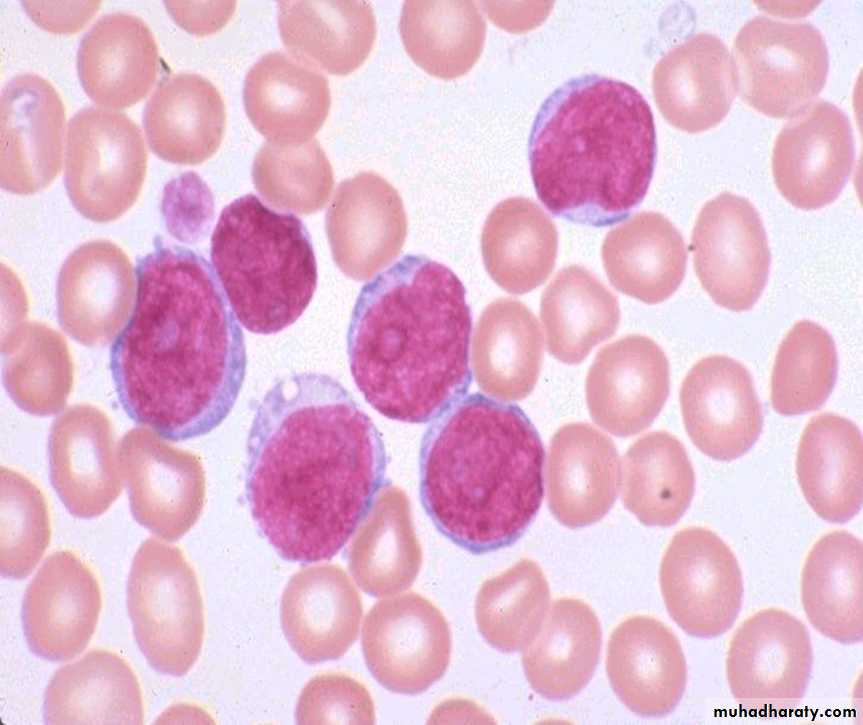

Pathology lab (mid year) review
Dr. Zainab. W. A. Alhayali.
1- Define the lesion?
Hypertrophy
2- Enumerate the adaptive responses to cell injury?
1- What is the lesion ?
Atrophy
2- Is this lesion always pathologic?
32 female presented with Gastroesophageal reflux.
Barrett esophagus1- Describe the endoscopic finding?
2- What is the significance of the microscopical finding?
40 years diabetic male presented with abnormal liver function test
Hepatic steatosis in an uncontrolled diabetus1- Description and diagnosis
2- list substances that can accumulate in cells?
1- what is the gross and microscopical diagnosis?
Gross infarctionmicroscopically coagulative necrosis
2- Provide two examples of liquefactive necrosis.
30 years female with fever ,sweating and hemoptysis .
Description and diagnosisLung tissue with caseous necrosis in a hilar lymph node appear grossly soft and greasy, resembling cottage cheese.
Name the special stain in the right photo
Acid fast stain
30 years female with fever and shortening of breathing.
1- define the lesion?Granulomatous inflammation
2- What are the main Cells and Mediators of this lesion?
Define this skin lesion ?
KeloidsHyperplastic scars composed of irregularly deposited bundles of collagen in the
dermis. They may appear as bulging masses extending beyond the confines of the original injury
60 years male with "right sided" heart failure. (liver)
Description and diagnosischronic passive congestion of the liver. dark red congested regions that represent accumulation of RBC's in centrilobular regions.
50 years male with sudden death .
1- what is the diagnosis?coronary artery showing the thrombus obstructing the whole lumen.
2- What are the main components of the hemostatic process?
• Vessel wall
• Platelets
• Coagulation proteins of the plasma
3- What are the macroscopic features of the lesion?
40 years female with sudden death.
Description and diagnosis.Pulmonary embolism
40 years old male with history of diarrhea containing blood and mucus (colon). 1- Describe & diagnose
Pseudo membranous colitis
2- What is the pathogenesis of the lesion
C. diffcile overgrows other intestinal flora in antibiotictreated people, releases toxins, and causes pseudomembranous colitis
1- Description and diagnosis
squamous papilloma2- What is the difference between carcinoma and sarcoma?
Malignant tumors of epithelial origin are called carcinomas.
Sarcomas are malignant tumors of connective tissue origin.
3- What is the difference between tumor invasion and metastasis?
Invasion local extension into the surrounding normal tissues.
Metastasis spread of tumors to sites that are anatomically separate
from their site of origin
1- Description and diagnosis
2- Give some other examples of malignant tumors ending in -oma.The suffix -oma attached to the cell or tissue of origin of a specific tumor is commonly used to name benign tumors (e.g., osteoma and fibroma). There are, however, some important exceptions to this rule
Glioma
Seminoma
Lymphoma
45 years male with ulcer in the dorsum of the hand
1- description and diagnosis.squamous cell carcinoma
2- What are the main differences between benign and malignant tumors? (2 only)
Excisional lymph node biopsy. How do tumors metastasize?
Tumors can metastasize three ways:• Lymphatic spread: Tumor cells invade the lymphatics and spread to local lymph nodes.
• Hematogenous spread: Tumor cells invade the blood vessels and are carried by blood to
distant sites.
• Seeding of body cavities: Tumor cells enter the cavities and float in the serous fluid to attach on the surface of the peritoneal or pleural cavity
30 years old female with pallor (blood film). Describe & diagnose
Acute leukaemia
Multiple myeloma1. BM infiltration by Plasma cells. 2. Skull X-ray shows multiple osteolytic lesionPractical Examination in Pathology
You have 4 slides, each has two minutes time, answer all the slides,do full description and make a final diagnosis ((Total mark 10 %Q 1) 70 years old male with supraclavicular lymph node enlargement. Describe & diagnose
Q 2) 65 years old female with shortness of breath (lung). Describe & diagnose
Q 3) 50 years old male with high fever and productive cough (lung) . Describe & diagnose
Q 4) 60 years old male with history of diarrhea with blood and mucus (colonic biopsy). Describe & diagnose